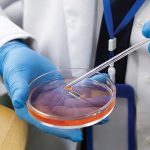
Kanserde Sıvı Biyopsi Nedir?

Kanser tanı ve tedavisinde kullanılan yöntemler, son yıllarda hızla gelişmektedir. Bu gelişmelerden biri de sıvı biyopsi olarak adlandırılan yenilikçi yaklaşımdır. Sıvı biyopsi, kanserin tanı, tedavi takibi ve hastalığın seyrini izleme sürecinde önemli avantajlar sunan, minimal girişimsel bir yöntemdir.
Geleneksel biyopsilerde tümörden doku alınması gerekirken, sıvı biyopside kan gibi vücut sıvıları incelenerek tümörle ilgili bilgi elde edilir. Bu yönüyle hem hasta konforunu artırır hem de hastalığın daha yakından takip edilmesine olanak tanır.
Sıvı Biyopsi Neyi İfade Eder?
Sıvı biyopsi, kanda dolaşan:
analiz etmeyi amaçlar. Kanser hücreleri büyüyüp çoğalırken kana küçük parçalar bırakır. Bu parçaların incelenmesi, tümör hakkında önemli bilgiler sunar.
Sıvı Biyopsi Nasıl Yapılır?
Sıvı biyopsi genellikle basit bir kan örneği alınarak gerçekleştirilir.
Bu özellikleri sayesinde hastalığın farklı evrelerinde birden fazla kez uygulanabilir ve tedavi süreci yakından izlenebilir.
Sıvı Biyopsi Hangi Alanlarda Kullanılır?
Sıvı biyopsi, kanserin birçok aşamasında destekleyici bir rol üstlenir:
1. Tedaviye Uygunluğun Değerlendirilmesi
Bazı tedavilerin etkili olabilmesi için tümörde belirli özelliklerin bulunması gerekir. Sıvı biyopsi, bu özelliklerin varlığı hakkında bilgi sağlayabilir.
2. Tedaviye Yanıtın Takibi
Uygulanan tedavinin işe yarayıp yaramadığını, kanda bulunan tümöre ait göstergelerdeki değişim üzerinden izlemek mümkün olabilir.
3. Direnç Gelişiminin Erken Fark Edilmesi
Bazı durumlarda tümör, zamanla uygulanan tedaviye direnç geliştirebilir. Sıvı biyopsi, bu değişikliklerin erken dönemde saptanmasına yardımcı olabilir.
4. Hastalık Nüksünün İzlenmesi
Tedavi sonrası dönemde, hastalığın yeniden ortaya çıkma riskinin erken sinyalleri sıvı biyopsi ile takip edilebilir.
Sıvı Biyopsinin Avantajları Nelerdir?
Bu yönleriyle sıvı biyopsi, klasik biyopsilerin yerine geçmekten çok, onları tamamlayıcı bir yöntem olarak değerlendirilir.
Her Hasta İçin Uygun mudur?
Sıvı biyopsi her durumda tek başına yeterli olmayabilir. Bazı kanser türlerinde veya erken evre hastalıklarda kanda yeterli düzeyde tümöre ait materyal bulunmayabilir. Bu nedenle sıvı biyopsi sonuçları, her zaman klinik bulgular ve diğer tanı yöntemleriyle birlikte değerlendirilmelidir.
Sıvı biyopsi, kanserin tanı ve takibinde daha az invaziv, daha hasta dostu ve daha esnek bir yaklaşım sunar. Özellikle tedavi sürecinin izlenmesi ve hastalığın seyrinin değerlendirilmesinde önemli katkılar sağlar.
Unutulmamalıdır ki sıvı biyopsi, tek başına bir tanı yöntemi değil, modern kanser yönetiminde kullanılan güçlü bir tamamlayıcı araçtır. Doğru hasta grubunda ve doğru zamanda kullanıldığında, kanserle mücadelede önemli bir avantaj sunabilir.